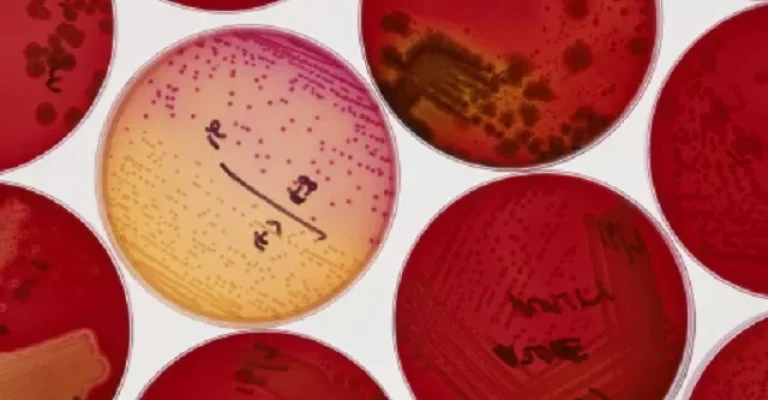
کشت باکتری در ژل آگار قرمز در ظروف پتری

لیوفیلیزاسیون باکتری: راهنمای جامع خشک کردن انجمادی کشت باکتریایی
مقدمهای بر لیوفیلیزاسیون (خشک کردن انجمادی)
خشک کردن انجمادی، که با نامهای لیوفیلیزاسیون یا کرایودسیکاسیون نیز شناخته میشود، فرآیندی است که در آن آب از یک محصول منجمد، با استفاده از خلاء حذف میشود. این کار به حفظ محصول بدون نیاز به حالت مایع کمک میکند، زیرا یخ مستقیماً به بخار تبدیل میشود.
در این فرآیند، یخ (یا سایر حلالهای منجمد) از طریق تصعید از محصول جدا شده و مولکولهای آب متصل، از طریق فرآیند دسربشن حذف میشوند.
نکات کلیدی
- خشک کردن انجمادی با استفاده از خلاء، آب را از محصول منجمد خارج میکند و آن را بدون نیاز به مایع، نگهداری میکند.
- لیوفیلیزاسیون برای نگهداری طولانیمدت باکتریها و سایر میکروارگانیسمها بدون آسیب، ایدهآل است.
- فرآیند خشک کردن انجمادی به تجهیزات خاصی مانند دستگاه فریز درایر و ویالهای استریل برای موفقیت نیاز دارد.
مبانی لیوفیلیزاسیون
یکی از بهترین روشها برای نگهداری طولانیمدت کشتهای باکتریایی، قارچی، مخمری و سایر میکروارگانیسمها، استفاده از فرآیند خشک کردن انجمادی است. این روش آزمایشگاهی نسبتاً ساده، با استفاده از هر دستگاه فریز درایر موجود در بازار قابل انجام است و به حفظ کلکسیون کشتهای شما کمک میکند.
از آنجایی که لیوفیلیزاسیون پیچیدهترین و گرانترین روش خشک کردن است، معمولاً برای مواد حساس به حرارت، مواد ظریف و با ارزش بالا مورد استفاده قرار میگیرد. موادی که در اثر انجماد آسیب نمیبینند، معمولاً میتوانند به روش لیوفیلیزاسیون خشک شوند، به طوری که دیگر نیازی به نگهداری در یخچال نباشد.
مدت زمان این فرآیند میتواند از سه ساعت تا ۲۴ ساعت (بدون احتساب زمان رشد کشت) متغیر باشد.
مواد و تجهیزات مورد نیاز
برای انجام فرآیند لیوفیلیزاسیون، به مواد و تجهیزات زیر نیاز خواهید داشت:
- دستگاه فریز درایر
- اتوکلاو
- پلیتهای آگار مغذی مناسب
- انکوباتور برای رشد کشت
- میله شیشهای
- بافر لیوفیلیزاسیون
- ویالهای دربدار با درپوش لاستیکی (و دستگاه پلمپ درپوش)
- فریزر
مراحل گام به گام لیوفیلیزاسیون
- کشت مورد نظر از میکروارگانیسم را روی پلیتهای آگار مغذی مناسب (مانند لوریابروس) کشت دهید و اجازه دهید یک شب بماند تا رشد کند.
- ویالهای دربدار را از قبل با اتوکلاو (استریلیزاسیون با استفاده از بخار، فشار و گرما) استریل کنید. درپوشهای لاستیکی را به صورت شل روی ویالها قرار دهید. قبل از اتوکلاو، برچسبهای کاغذی حاوی مشخصات کشت را داخل ویالها قرار دهید. یا از ویالهایی با درپوش طراحی شده برای استریلیزاسیون استفاده کنید.
- ۴ میلیلیتر بافر لیوفیلیزاسیون به پلیت اضافه کنید. در صورت نیاز، سلولها را با استفاده از یک میله شیشهای استریل معلق کنید.
- به سرعت سوسپانسیون کشت را به ویالهای استریل منتقل کنید. تقریباً ۱.۵ میلیلیتر در هر ویال بریزید. با درپوش لاستیکی ویال را ببندید.
- سوسپانسیون کشت داخل ویالها را با قرار دادن ویالها در فریزر با دمای منفی ۲۰ درجه سانتیگراد منجمد کنید.
- پس از انجماد کشتها، دستگاه فریز درایر را روشن کنید و اجازه دهید تا دما و شرایط خلاء مناسب تثبیت شود. این کار را طبق دستورالعمل سازنده دستگاه انجام دهید.
- به آرامی و به صورت استریل، درپوشهای ویالها را به صورت شل روی ویالها قرار دهید تا رطوبت در طول فرآیند خشک کردن انجمادی خارج شود. ویالها را داخل محفظه دستگاه فریز درایر قرار دهید و طبق دستورالعمل سازنده، خلاء را اعمال کنید.
- به کشت زمان دهید تا کاملاً لیوفیلیزه (خشک) شود. این ممکن است بسته به حجم هر نمونه و تعداد نمونهها، از چند ساعت تا یک شب طول بکشد.
- نمونهها را طبق دستورالعمل سازنده از محفظه دستگاه فریز درایر خارج کرده و بلافاصله ویالها را با درپوش لاستیکی ببندید و پلمپ کنید.
- کلکسیون کشت لیوفیلیزه شده را در دمای اتاق نگهداری کنید.
- شیمی
- علم



